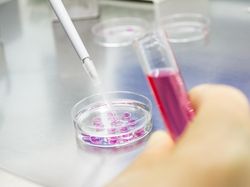
Temuan Mengejutkan di 2022: Bahtera Nuh dan Virus Purba Bangkit Lagi

Year In Review 2022
Rabu, 28 Des 2022 06:36 WIB
Year In Review 2022
Rabu, 28 Des 2022 06:36 WIB
9 Mobil Listrik Paling Laku di Indonesia Tahun 2022
Selama Januari hingga dengan November 2022, ribuan unit mobil listrik terjual di Indonesia. Nah, mobil apa sih yang paling laris? Simak foto-fotonya berikut ini